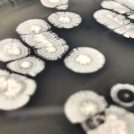

Éra Clean BioSol

Éra Clean BioSol est un agent nettoyant concentré à pH neutre combinant les forces de la chimie verte et de la biotechnologie. La formulation est à la fois puissante, durable, écologique et sécuritaire pour les utilisateurs et les équipements. Après le nettoyage, Éra Clean BioSol introduit des bactéries bénéfiques qui aident à prévenir l’apparition de maladies bactériennes, fongiques ou d’insectes ravageurs.
 Pour le milieu serricole
Pour le milieu serricole
Éliminer les souillures solides et liquides non adhérentes puis humidifier le plancher. Avec une vadrouille ou une autorécureuse, appliquer Éra Clean BioSol sur les surfaces à nettoyer selon le type de souillure.

Principaux avantages :
Nettoie et dégraisse durablement les planchers grâce aux biotechnologies enzymatiques.
Relâche des bactéries bénéfiques qui limitent l’apparition de microorganismes indésirables.
Réduit l’accumulation de matière organique.
Mode d'action :
- Souches bactérienne productrice d'enzymes dégradeur de matières organiques. élimine les niches de développement potentiel de maladie.
- Nos souches bactérienne bénéfiques entre en compétition avec les possibles microorganismes pathogène de l'environnement.
- Agit à titre de première barrière biologique contre les maladies. C'est le pouvoir de notre système d'ingénierie du microbiome de la serre.
- Agent nettoyant écologique doux et pH neutre
Fiche de données de sécurités
Pour une utilisation optimale et sécuritaire de notre produit Era Clean BioSol, veuillez vous référer à sa fiche de données de sécurité.


Ingénierie du microbiome
Cultiver un microbien sain au sein de votre serre assure un environnement de croissance végétale optimal et réduit significativement les risques d'implantation de maladies qui peuvent occasionner des pertes financières. Notre système d'ingénierie du microbiote représente une révolution dans le domaine de l'hygiène des serres. Prenez le contrôle de vos cultures grâce à notre gamme de produits Éra Clean!
Tableau d'application
 Type de culture Type de culture |
 Taux d'application Taux d'application |
 Fréquence Fréquence |
|---|---|---|
|
Souillures légères
|
|
|
|
Souillures majeures
|
|
|